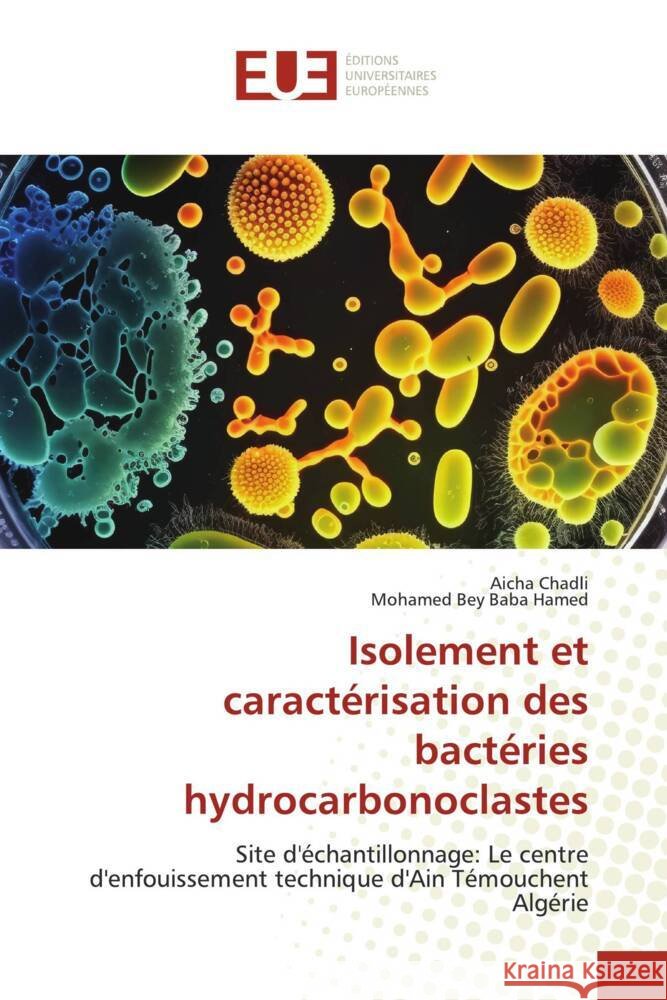
Isolement et caractérisation des bactéries hydrocarbonoclastes Chadli, Aicha, Baba Hamed, Mohamed Bey 9786203458121

Wyniki wyszukiwania:
wyszukanych pozycji: 21
 |
Cours de Biologie cellulaire
ISBN: 9786206690320 / Francuski / Miękka / 100 str. Termin realizacji zamówienia: ok. 10-14 dni roboczych. La biologie cellulaire (cytologie) est une discipline scientifique qui étudie les cellules, du point de vue structural et fonctionnel, et les utilise pour des applications en biotechnologie. Elle s'intéresse à l'écosystème cellulaire, c'est-à-dire à l'équilibre dynamique et autorégulé des fonctions cellulaires, dans un contexte normal ou perturbé. Le champ de la biologie cellulaire concerne une multitude de réactions chimiques coordonnées et de mécanismes fins de régulation entre des millions de constituants micro et nanoscopiques. Ces constituants assurent durablement...
La biologie cellulaire (cytologie) est une discipline scientifique qui étudie les cellules, du point de vue structural et fonctionnel, et les utilise...
|
cena:
276,89 |
 |
Corso di biologia cellulare
ISBN: 9786206862314 / Włoski / Miękka / 76 str. Termin realizacji zamówienia: ok. 10-14 dni roboczych. |
cena:
276,89 |
 |
Curso de Biologia Celular
ISBN: 9786206862338 / Portugalski Termin realizacji zamówienia: ok. 10-14 dni roboczych. |
cena:
276,89 |
 |
Cell Biology Course
ISBN: 9786206862291 / Angielski Termin realizacji zamówienia: ok. 10-14 dni roboczych. |
cena:
276,89 |
 |
Kurse in Zellbiologie
ISBN: 9786206862284 / Niemiecki Termin realizacji zamówienia: ok. 10-14 dni roboczych. |
cena:
276,89 |
|
Isolement et caractérisation des bactéries hydrocarbonoclastes
ISBN: 9786203458121 / Francuski / Miękka / 136 str. Termin realizacji zamówienia: ok. 10-14 dni roboczych. L'analyse microbiologique des bactéries biodégradantes des hydrocarbures isolées à partir du lixiviat récolté du C.E.T d'Ain Témouchent, a révélée qu'elles appartenaient à la famille des Pseudomonadaceae et des Staphylococcaceae. Les tests biochimique sont ont ainsi révélé la présence de : Pseudomonas aeruginosa (Ps), Pseudomonas fluorescens (38) et Pseudomonas sp (98), Staphylococcus aureus (St), Staphylococcus xylosus (5), Staphylococcus hominis (78) et Staphylococcus warnerii (28). Ces dernières ont fait l'objet d'une caractérisation moléculaire, par l'extraction de l'ADN...
L'analyse microbiologique des bactéries biodégradantes des hydrocarbures isolées à partir du lixiviat récolté du C.E.T d'Ain Témouchent, a rév...
|
cena:
313,26 |
 |
La biodégradation du glyphosate
ISBN: 9786206697756 / Francuski / Miękka / 84 str. Termin realizacji zamówienia: ok. 10-14 dni roboczych. Le glyphosate (N-phosphonométhylglycine) est l'herbicide le plus couramment utilisé dans le monde entier et en Algérie. Connaître les bactéries capables de le dégrader est d'un grand intérêt. Ainsi, dans cette étude trente souches bactériennes ont été isolées, par des cultures d'enrichissement, à partir de trois sols de la région de Mostaganem traités avec différents herbicides (Glyphosate, Métribuzine et Linuron).Ces isolats bactériens ont montré des niveaux de croissance élevés en présence du glyphosate comme seule source de carbone, elles ont donc été utilisées...
Le glyphosate (N-phosphonométhylglycine) est l'herbicide le plus couramment utilisé dans le monde entier et en Algérie. Connaître les bactéries c...
|
cena:
199,59 |
 |
Glyphosate biodegradation
ISBN: 9786206850649 / Angielski / Miękka / 72 str. Termin realizacji zamówienia: ok. 10-14 dni roboczych. Glyphosate (N-phosphonomethylglycine) is the most commonly used herbicide worldwide and in Algeria. Knowledge of the bacteria capable of degrading it is of great interest. Thus, in this study, thirty bacterial strains were isolated, by enrichment cultures, from three soils in the Mostaganem region treated with different herbicides (Glyphosate, Metribuzin and Linuron).These bacterial isolates showed high growth levels in the presence of glyphosate as the sole carbon source, so they were used for optimization studies of abiotic parameters for efficient glyphosate degradation. Twelve strains...
Glyphosate (N-phosphonomethylglycine) is the most commonly used herbicide worldwide and in Algeria. Knowledge of the bacteria capable of degrading it ...
|
cena:
199,59 |
 |
Isolierung und Charakterisierung von Hydrocarbonoklasten-Bakterien
ISBN: 9786206670216 / Niemiecki Termin realizacji zamówienia: ok. 10-14 dni roboczych. |
cena:
313,26 |
 |
Isolamento e carateriza??o de bact?rias hidrocarbonoclastas
ISBN: 9786206670261 / Portugalski Termin realizacji zamówienia: ok. 10-14 dni roboczych. |
cena:
313,26 |
 |
Isolamento e caratterizzazione dei batteri idrocarbonoclasti
ISBN: 9786206670247 / Włoski Termin realizacji zamówienia: ok. 10-14 dni roboczych. |
cena:
313,26 |
 |
Isolation and characterization of hydrocarbonoclast bacteria
ISBN: 9786206670223 / Angielski Termin realizacji zamówienia: ok. 10-14 dni roboczych. |
cena:
313,26 |
 |
Evaluation du potentiel probiotique de souches lactiques du lait bovin
ISBN: 9786203457865 / Francuski / Miękka / 116 str. Termin realizacji zamówienia: ok. 10-14 dni roboczych. L'utilisation des bactéries lactiques en industrie laitière a connu une énorme évaluation dans les pays technologiquement avancés, l'exploitation de ce genre est par contre très limitée dans certains autres pays comme l'Algérie, cette limitation concerne la diversité des produits présents sur la marché mais également le nombre des souches introduites dans les produits laitiers, cela est liée aux contraintes posées par les bactéries lactiques. La présente étude a pour objectif principal d'isoler de nouvelles bactéries lactiques à partir du lait de vache et de tester leur...
L'utilisation des bactéries lactiques en industrie laitière a connu une énorme évaluation dans les pays technologiquement avancés, l'exploitation...
|
cena:
276,89 |
 |
Bactéries lactiques du lait de chèvre algérien
ISBN: 9786209534683 / Francuski / Miękka / 2026 / 120 str. Termin realizacji zamówienia: ok. 10-14 dni roboczych. Cette étude vise à caractériser les propriétés technologiques des bactéries lactiques isolées du lait cru de chèvre de la région de Mesra (Mostaganem), dans le contexte de la valorisation des levains lactiques locaux en Algérie. Quarante souches ont été isolées après fermentation spontanée et évaluées pour leurs capacités acidifiantes, protéolytiques et aromatiques. Quatre souches sélectionnées ont été utilisées comme levains pour la fabrication de yaourts et de fromages frais, conformes aux normes physicochimiques et microbiologiques. Les résultats sensoriels et...
Cette étude vise à caractériser les propriétés technologiques des bactéries lactiques isolées du lait cru de chèvre de la région de Mesra (Mo...
|
cena:
276,89 |
 |
La biodegradazione del glifosato
ISBN: 9786206850700 / Włoski Termin realizacji zamówienia: ok. 10-14 dni roboczych. |
cena:
199,59 |
 |
A biodegrada??o do glifosato
ISBN: 9786206850670 / Portugalski Termin realizacji zamówienia: ok. 10-14 dni roboczych. |
cena:
199,59 |
 |
Der biologische Abbau von Glyphosat
ISBN: 9786206850656 / Niemiecki Termin realizacji zamówienia: ok. 10-14 dni roboczych. |
cena:
199,59 |
 |
Avalia??o do potencial probi?tico de estirpes l?cticas do leite de bovino
ISBN: 9786206857648 / Portugalski Termin realizacji zamówienia: ok. 10-14 dni roboczych. |
cena:
276,89 |
 |
Valutazione del potenziale probiotico di ceppi lattici da latte bovino
ISBN: 9786206857631 / Włoski Termin realizacji zamówienia: ok. 10-14 dni roboczych. |
cena:
276,89 |
 |
Evaluation of the probiotic potential of lactic strains from bovine milk
ISBN: 9786206857617 / Angielski Termin realizacji zamówienia: ok. 10-14 dni roboczych. |
cena:
276,89 |











